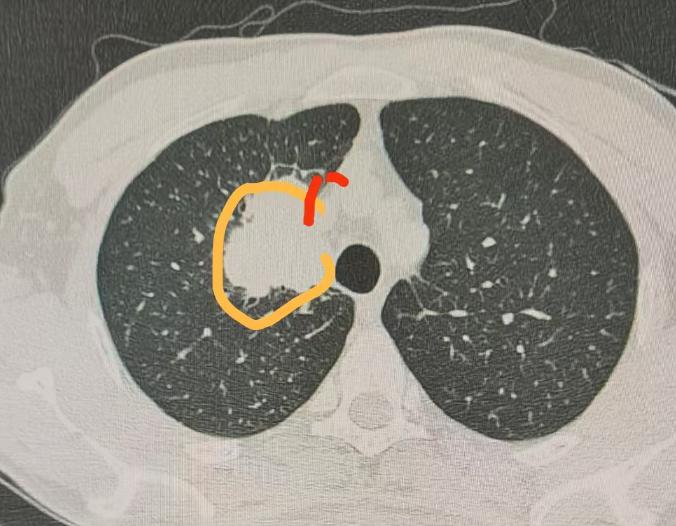

刚完成一台右上肺癌手术,这位患者一周前,曾在外院接受过肺癌手术,但因为术中医生发现肿瘤侵犯上腔静脉,所以手术就没给他做成。 经过我对患者影像资料的详细分析,PET-CT显示无淋巴结转移,奇静脉弓区域较为干净,肺动脉主干状态尚可。 问题的关键在于肿瘤与上腔静脉紧密粘连,侵犯严重,导致手术难以进行。但在纵隔窗影像中可见,侵犯范围较为局限,仅集中于上腔静脉局部区域。 尽管肿瘤与血管粘连紧密,但肺动脉主干以下部分未受侵犯,且全身未见转移。此外,右肺中叶的结节经判断为结核性,不影响手术决策。 综合考虑,患者仍有望通过手术获益,且病灶靠近上腔静脉,活检难度大,风险高,因此多数医生不愿进行穿刺。 今日我为患者实施了开胸手术,切口约15cm。术中控制上腔静脉的远端与近端,确保操作安全。 随后完成右上肺切除,并对受侵犯的上腔静脉侧壁进行切除与吻合,手术过程顺利,出血控制良好。 这一案例提示我们,在肿瘤治疗中,不应一味追求微创。虽然微创手术创伤小、恢复快是重要目标,但实现肿瘤的彻底切除与手术安全更为关键! 此次手术虽切口较长,但在大血管控制到位的前提下,出血极少,整体效果理想。[作揖][玫瑰]